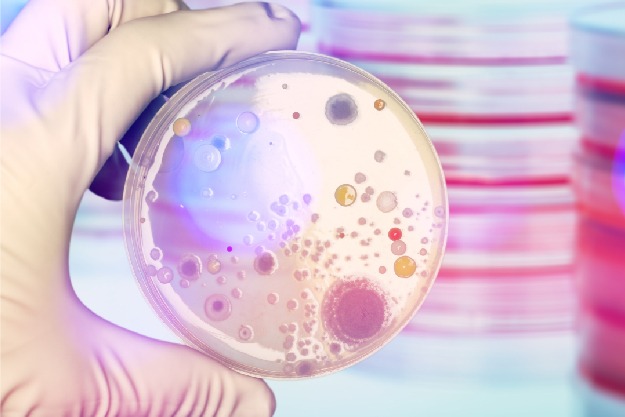

A Unijuí está ofertando a 2ª edição da qualificação profissional de Diagnóstico Laboratorial em Micologia. A formação é destinada aos estudantes e profissionais da área da saúde. As inscrições podem ser realizadas até 15 de outubro, pelo site.
Essa formação tem carga horária de 8h, com aula presencial que une teoria e prática, por meio do conteúdo programático sobre a classificação fúngica e diagnóstico laboratorial das micoses de maior prevalência.
A aula será realizada no dia 28 de outubro, no campus Ijuí, no turno da manhã das 8h30 às 12h, e à tarde, das 13h às 17h.
Para mais informações sobre esta e outras qualificações, acesse unijui.edu.br/estude/educacao-continuada/qualificacao-profissional ou entre em contato pelo telefone (55) 3332-0553, WhatsApp (55) 99180-6755 ou pelo e-mail estude@unijui.edu.br.